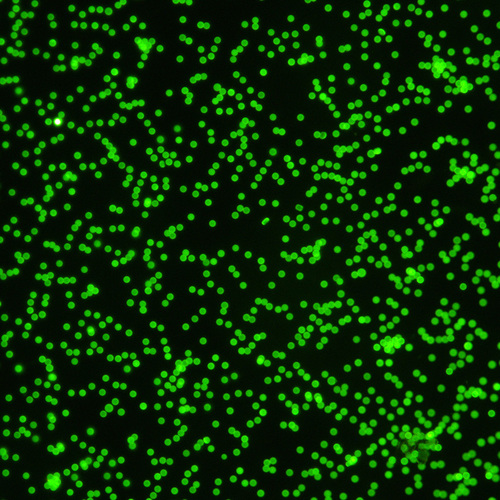
1112.jpg

HMDI 相机
 USB 相机
 荧光相机
 荧光制冷
 高灵敏度相机是指成像器件能探测到光子数小于500个,在微弱光环境下进行成像。例如在显微镜下观察细胞的荧光图像时,由于光强度很小用普通的CCD相机或者人眼看不清图像,并且有用的图像信息被噪声所掩盖。在客观上无法增加光强度的情况下,需要使用高灵敏度相机来完成成像的任务。 一、高灵敏度相机的应用领域 高灵敏度相机的应用领域主要是用在生命科学、材料科学、生物化学和天文学等无法使用照明或照明不足或需要更清晰图像的领域等方面,包括: 1、没有照明的领域:荧光/发光观察;发光体和闪烁体的观察;天文观测;光谱仪读数;放电观察。 2、光线不足的领域:使用干涉滤光片进行单色波长观察;激光激发的荧光观察;观察生物细胞;夜间监控。 3、需要更清晰图像的领域:观察低对比度的物体;高精度测量。 二、在选择高灵敏度相机时着重考虑如下重要指标: 1、信噪比 2、量子效率 3、像素大小 4. 冷却温度 5. A/D转换(动态范围)  该相机适用于细胞荧光分析、血细胞观察、液基细胞分析、免疫组化、骨髓细胞分析等对颜色要求高的研究应用,同时在明暗场、相衬、偏光、DIC成像观察等领域也表现出色。 特点: ▶ 在低倍镜下拍摄的图像,即使放大数倍也依然清晰。 ▶ 具有高分辨率、高灵敏度、高动态范围、高帧率、高对比度和原色还原准确。 ▶ 提供完整的图像采集-编辑--测量-报告输出列工作流,优化操作流程,节省时间。 下图是微球粒子荧光成像的应用:
● 高灵敏度荧光相机,高感光芯片 ● 适用于生命科学领域、生物医疗、荧光成像
|